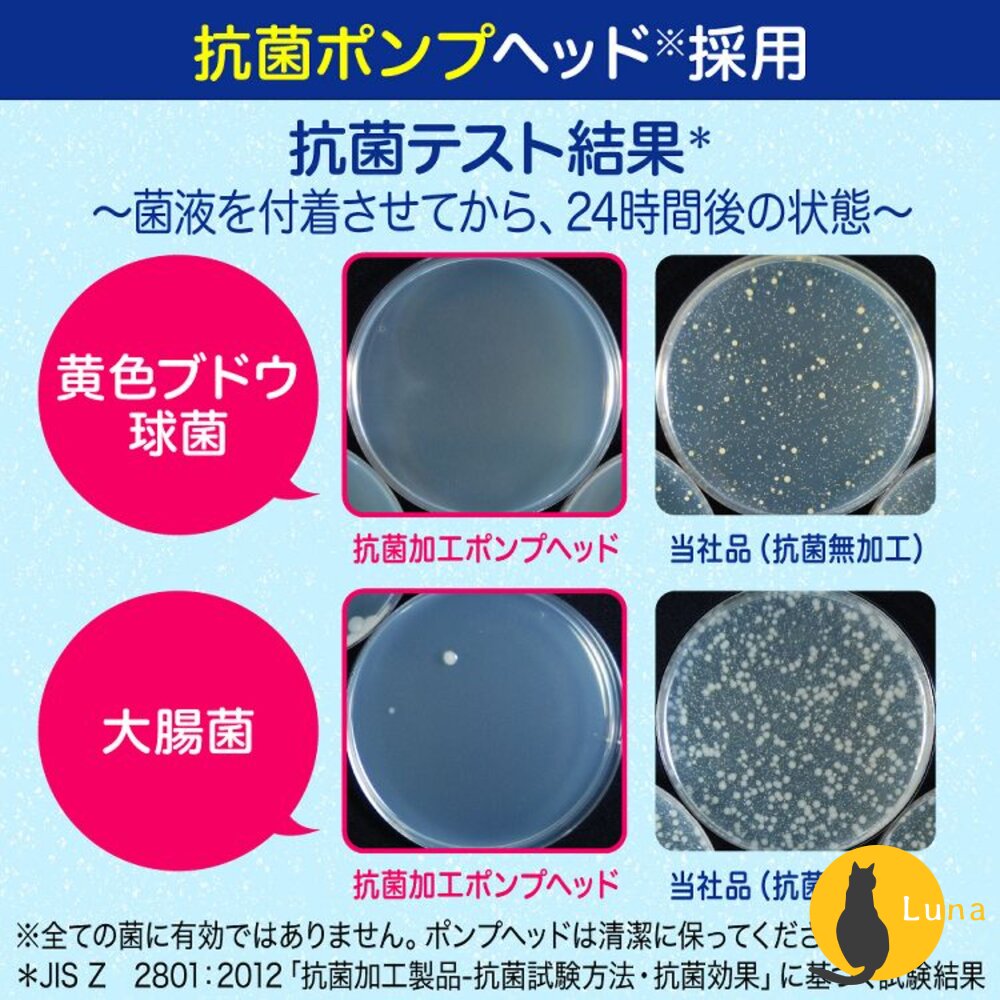
無香新上架 日本境內 花王 Kao Biore 洗手慕斯 泡沫慕斯 洗手泡泡 弱酸性 溫和 抗菌 洗手乳-圖片-6

日本 地球製藥 洗手台 水管 清潔泡泡 馬桶清潔 浴廁清潔 泡沫噴霧 浴缸清潔 EARTH
$103
商品圖片

庫存表
| 規格 | |
|---|---|
| 花王洗手慕斯壓瓶240ml(藍色皂香) | 現貨 71 件 |
| 花王洗手慕斯壓瓶240ml(粉色果香) | 現貨 74 件 |
| 花王洗手慕斯壓瓶240ml(綠色柑橘) | 現貨 81 件 |
| 花王洗手慕斯壓瓶240ml(銀無香料) | 現貨 75 件 |
商品描述
ζ✿單筆訂單商品金額滿NT$150(不含運費)即可出貨,未滿額無法出貨並會E-mail通知,訂單取消造成的權益受損恕不另行補償,造成不便敬請見諒><✿
-
ζ✿本小舖2024年起採用光貿開立雲端電子發票,以會員資料中的E-mail為載具,發票開立後會mail給您,發票預設為二聯式發票,若有打統編(三聯式發票)或手機條碼歸戶需求請下單時一併備註,謝謝您✿
-
@超商有5公斤限制,此商品一筆訂單最多12瓶@
【花王泡沫洗手慕斯壓瓶】
日本Biore限定款!泡沫慕絲洗手乳
💡徹底清潔、帶走異味!
💡日本主婦廚房必備好物
💡溫和弱酸性配方 全家人適用
💡弱酸性配方溫和不易刺激,洗後水嫩不乾澀
💡綿密細緻的泡泡 輕柔洗去髒污
💡一按即出綿密慕絲泡泡,輕鬆洗淨指縫污垢與異味
規格:240ml
產地:泰國(其他三款有香味的);日本(無香料)
保存期限:未開封三年
@個人衛生用品,一經拆封即不適用七天鑑賞期,無法退換貨@
-
【備註】
※網頁商品會因為使用不同的品牌螢幕及解析度不同,造成圖片顏色呈現略有不同,請以實品顏色為準。
※因日本時常更換商品包裝,若圖片無及時更換請見諒,請以實物包裝為準。
※此為個人衛生用品,一經拆封即不適用七天鑑賞期,無法退換貨。
運送與付款
運送方式:7-11, 全家, 萊爾富, OK超商, 宅配, 自行取貨付款
付款方式:現金, 線上刷卡, ATM轉帳, 超商取貨付款
供貨模式:現貨
配送溫層: 常溫